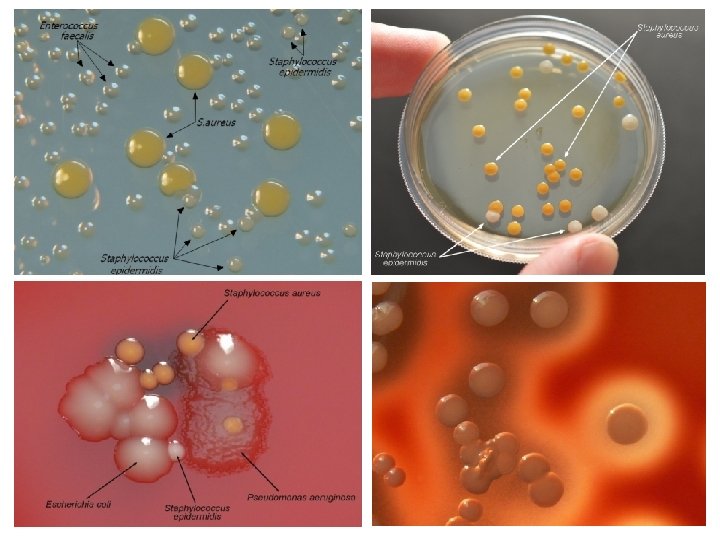

STAPHYLOCOCCUS Skin upper respiratory tract lower digestive system























- Slides: 23

STAPHYLOCOCCUS

• Skin, upper respiratory tract, lower digestive system and urogenital system (all mucosal) • Opportunistic pathogen • Mastitis (60 -70%) • Lamb of pyemia Ø The irrational apse builds up abscess in other tissues (tick pie) • Botryomycosis in horses Ø Chronic, irritable, granulomatous wound • Irritable infections • Nosocomial infections (MRSA)


Family: Genus: Species: Staphylococcaceae Staphylococcus S. aureus, S. intermedius, More than 30 species S. pseudintermedius, S. hyicus, S. epidermidis

• Gram-positive cocci • Tend to create irregular stacks (grape bunches) • Asporous, nonmotile • Facultative anaerobic (fermentative) • Catalase positive • Oxidase negative • Can grow in simple environments • Optimal 30 -37 ° C (10 -42 ° C) • Form pigmented colony ü S. aureus: golden yellow ü S. epidermidis (albus): White ü S. citreus: lemon yellow

Gram stain Staphylococus spp.

Staphylococus are catalase positive

• Colony morphology • Staphylococci form colonies of S type, usually white in color and bright, reaching up to 4 mm in diameter – S. aureus strains of bovine and human origin colonies are in golden color form – Some coagulase negative staphylococcal colonies are also pigmented – Make homogeneous turbidity in liquid medium • Hemolysis on blood agar • S. aureus and S. intermedius strains of animal origin form both alpha- and betahemolysis • Alpha hemolysis: complete hemolysis in a narrow zone immediately around the colony • Beta-hemolysis: partial or incomplete hemolysis in a wider zone. Also called double zone hemolysis. These toxins act as toxins in vivo conditions. S. hyicus isolates are non-hemolytic.

Staphylococcal Hemolysis Alpha Beta Gamma Type of Hemolysis Complete Half Erythrocytes Features Sensitive Insensitive Rabbit Sheep Cattle Horse Human Chicken Cytolysis Rabbit Takes role in phospholipase and CAMP test Sheep

Staphylococcus aureus

Staphylococcus epidermidis

ANTIGENIC STRUCTURE PEPTIDOGLYCAN TEICHOIC ACIDS — Alcohol part is ribitol in S. aureus — In glycerol structure in S. epidermidis and S. intermedius PROTEIN A – – It is found in strains of Virulent S. aureus (Cowan 1 strain) The Ig. G binds through the Fc part Anti-phagocytic factor Dependent on cell wall or partly releasable Coagulase – Free coagulase – Clumping factor (bound coagulase)

Koagulase Test (Pathogen-Apathogenic Staphylococcus Differentiation)

Locations • Very common in mammals • In the nasal cavity, skin, mucous membranes • They are temporarily found in the digestive tract • The infections they create are usually endogenous

Pathogenicity • Staphylococci are pyogenic microorganisms; related to abscess and irritation • The circumference of abscesses is surrounded by a fibrous capsule • In chronic staphylococcal wound infections (botryomycosis), the lesions are granulomas formed by pus • Pathogenic staphylococci produce a large number of toxins and enzymes

Type of Staphylococcus S. aureus S. intermedius S. pseudintermedius Affected Animals Disease Many animal species Infections with abscess and pus. Infection may be systemic Cow Mastitis (subclinical, chronic, acute, peracute, gangrenous) Sheep Mastitis (acute, peracute, gangrenous), tick pyemia in lamb, periorbital eczema, staphylococcal dermatitis Goat Mastitis (subacute, peracute), staphylococcal dermatitis Pig Mastitis (acute, subacute, cronic), necrotic endometritis Horse Mastitis (acute), botryomycosis after castration Rabbit Exudative dermatitis in newborns, abscess, conjunctivitis Chicken Purulent granulomatous formations in the subcutaneous tissue of feet and articulations, “Bumble-food” Cat, dog Purulent lesions Cat, dog Canine (feline) pyoderma, pyometra, sistitis, otitis externa Respiratory system, bone, articulation and wound infections Pig S. hyicus Exudative epidermitis, Septic polyarthritis

Piyemia of lamb (tick) • • • Ixodes ricinus S. aureus enters the skin lesion In 2 -10 week old lambs In spring-summer Septisemic, characterized by sudden death Numerous abscesses in internal organs of necropsy

Exudative Epidermitis • Agent is S. hyicus • In piglets • Bacteria found in the skin and vaginal mucosa enters the wound • Exfoliation of the skin is seen

• Pathogenic Staphylococci – S. aureus, S. intermedius, S. pseudintermedius, S. hyicus (most) coagulase positive • Coagulase negative staphylococci (CNS) – S. epidermidis, S. saprophyticus • Staphylococci are resistant to bacitracin • S. aureus is the agent of chronic mastitis, CNS are the agent of subclinical mastitis

Coagula Catalase Oxidase se Pathogenic O/F Hemolysi s + + - F +/- Streptococci - - - F + Micrococci - + + O +/- Staphylococci Apathogenic Staphylococci

Catalase Negative Staphylococcus? • • Staphylococcus aureus subsp. anaerobius Catalase Coagulase + It causes 'lymphadenitis' -like lesions which Corynebacterium pseudotuberculosis causes